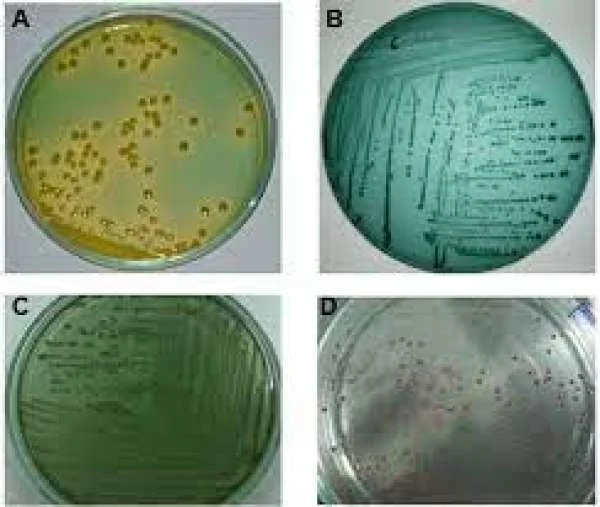
Bệnh do Vibrio spp: Nguyên nhân, triệu chứng và cách phòng tránh

Bệnh đầu vàng ở tôm: Nguy hiểm tiềm ẩn và biện pháp phòng tránh
Bệnh Đầu Vàng ở Tôm: Dấu Hiệu, Phòng và Xử Lý
Bệnh Đầu Vàng ở Tôm: Dấu Hiệu và Khả Năng Gây Hại
Bệnh đầu vàng (Yellow Head Disease - YHD) là một trong những căn bệnh nguy hiểm gây tổn thất kinh tế trong ngành nuôi tôm. Bệnh này do virus hình que yellow head virus gây ra, có bộ gen acid nhân RNA chuỗi đơn, kích thước 44 x 173 nm.
Hình Ảnh 1.1: TÔM THẺ BỊ ĐẦU VÀNG
Dấu hiệu đặc trưng của bệnh đầu vàng là sự phát triển nhanh chóng của căn bệnh. Ban đầu, tôm bắt đầu ăn nhiều hơn bình thường trong một thời gian ngắn, sau đó đột ngột ngừng ăn và trở nên lờ đờ, dạt bờ và chết. Phần đầu, mang và gan tụy của tôm chuyển sang màu vàng nhạt hoặc nâu, toàn thân trở nên nhợt nhạt và mất màu sắc đặc trưng. Một số tôm có thể thể hiện dấu hiệu này mạnh hơn, trong khi một số khác có thể không biểu hiện rõ ràng.
Phòng và Xử Lý Bệnh Đầu Vàng ở Tôm
Hình Ảnh 1.2: TÔM THẺ TỐT VÀ PHÁT TRIỂN SAU KHI CÓ PHƯƠNG PHÁP NGỪA.
Hiện chưa có phương pháp trị bệnh đầu vàng một cách hiệu quả. Tuy nhiên, biện pháp phòng ngừa và quản lý có thể giảm nguy cơ lây nhiễm và giảm thiểu thiệt hại:
- Chuẩn Bị Ao Nuôi: Trước mỗi vụ nuôi, nạo vét và phơi rửa đáy ao một cách tốt để loại bỏ tất cả các chất cặn bã và tạo môi trường sạch.
- Rào Lưới Ao Nuôi: Lắp đặt lưới rào quanh ao nuôi để ngăn chặn các loài giáp xác trung gian mang mầm bệnh vào ao.
- Xử Lý Nước: Đảm bảo nước cấp vào ao đã được xử lý và diệt trùng đầy đủ theo quy định.
- Bổ Sung Men Vi Sinh: Bổ sung men vi sinh vào ao để tạo hệ vi sinh có lợi, kiềm hãm mầm bệnh và cân bằng môi trường nước.
- Giám Sát Môi Trường: Theo dõi các chỉ số môi trường như oxy, độ kiềm, pH để đảm bảo ngưỡng thích hợp cho tôm.
- Dinh Dưỡng Hợp Lý: Cung cấp dinh dưỡng cần thiết bằng cách bổ sung khoáng chất và vitamin, đặc biệt là vitamin C để tăng sức đề kháng cho tôm.
- Xử Lý Nước Thải: Xử lý nước thải từ ao nuôi bị nhiễm bệnh trước khi thải ra môi trường bên ngoài.
Dù chưa có biện pháp trị bệnh, việc thực hiện các biện pháp phòng bệnh có thể giúp hạn chế tình trạng lây nhiễm và giảm thiểu thiệt hại kinh tế trong ngành nuôi tôm. Để duy trì sức khỏe của tôm và nguồn thu nhập của hộ nuôi, việc áp dụng các biện pháp phòng bệnh là vô cùng quan trọng.